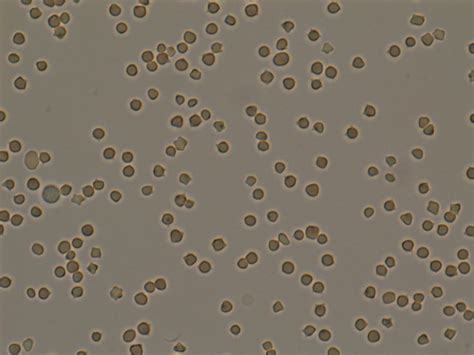
whats  deal   saline agglutination test

Jika kamu sedang mencari Saline Microscope, maka anda berada di halaman yang tepat. Kami menyediakan aneka Saline Microscope yang bisa anda pesan online. Silakan hubungi kami via +6282245078486, jangan lupa sertakan juka gambar yang diinginkan.
Kami mengirim paket Saline Microscope melalui berbagai ekspedisi, misalnya JNE, JNT, POS, dll. Kami juga menerima pembayaran via BCA/Mandiri/dll. Pengiriman biasanya tidak sampai seminggu sudah sampai dan kami sertakan pula nomor resi yang bisa digunakan untuk tracking barang secara online.

Tidak hanya Saline Microscope, anda juga bisa melihat gambar lain seperti
Saline IV Fluids,
Nasal Spray,
Eye Wash Solution,
Sinus Rinse,
Tattoo Removal,
Solution PNG,
Dressing for Wound Care,
Glass Bottle,
Wound Cleanser,
Water Solution,
Sodium Chloride,
Contact Lens,
Eye Solution,
Bacteriostatic Normal,
Drops for Nose,
Ampoules,
NaCl,
Phosphate Buffer,
Sinus,
Solution Nasal Spray,
Arm Hammer Nasal,
and Medicine.
Berbagai Contoh Saline Microscope
Berikut kami sertakan berbagai contoh gambar untuk Saline Microscope, silakan save gambar di bawah dengan klik tombol pesan, anda akan kami arahkan pemesanan via WA ke +6282245078486.
 1000×668
1000×668
double exposure normal saline microscope stock photo adobe stock
Order Sekarang
 347×280
347×280
image onion pulp cells saline microscope stock photo
Order Sekarang
 507×338
507×338
saline solution microscope hospital stock photo image
Order Sekarang
 850×843
850×843
scanning electron microscope images recovered samples saline
Order Sekarang
 850×864
850×864
light electron microscope micrographs cont saline ds
Order Sekarang
 768×768
768×768
normal saline medico flocked swabssampling swabchg swab stick
Order Sekarang
 1300×1341
1300×1341
salt microscope res stock photography images alamy
Order Sekarang
 1071×714
1071×714
salt crystal microscope smithsonian photo contest
Order Sekarang
 1024×576
1024×576
saline wet mount microscopy introduction principle preparation result
Order Sekarang
 1600×1156
1600×1156
sea salt macro photography magnified microscope stock
Order Sekarang
 338×620
338×620
salivary gland microscope hematoxylin stock photo
Order Sekarang
 600×600
600×600
sterile saline ml pods school science equipment
Order Sekarang
 390×280
390×280
infusion iv drip saline solution bottle stock photo
Order Sekarang
 260×280
260×280
microscopic view saline seawater mixing freshwater ai generated image
Order Sekarang
 1333×2000
1333×2000
sea salt macro photography magnified microscope premium ai
Order Sekarang
1024×576
1024×576
saline wet mount microscopy introduction principle test requirements
Order Sekarang
 1300×956
1300×956
salt crystals microscope light micrograph close view stock
Order Sekarang
 4032×2268
4032×2268
swift swdl compound monocular microscope review science
Order Sekarang
Temukan solusi terbaik untuk kenyamanan ruang Anda dengan Saline Microscope! Produk peredam suara dan panas ini menawarkan performa maksimal dengan harga yang terjangkau. Dapatkan kualitas unggul tanpa menguras kantong, dan nikmati suasana tenang serta sejuk di setiap sudut rumah atau kantor Anda. Pilih Saline Microscope – pilihan cerdas untuk investasi jangka panjang!
Maaf, tidak ada yang cocok dengan kriteria yang Anda cari.
Apa yang ingin Anda lakukan?
« kembali ke Beranda atau gunakan kotak pencarian dibawah ini untuk mulai penelusuran baru.










